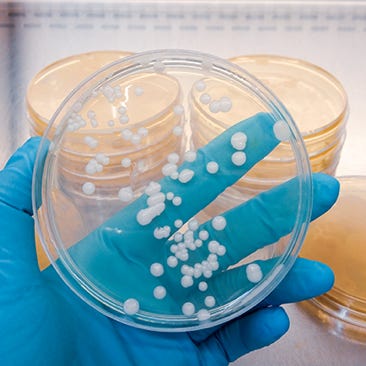

Particle Counting
Particle counting per ISO14644-1 measures airborne particles using calibrated counters at defined locations to verify cleanroom classification. It ensures compliance with particle limits, supporting product quality, regulatory standards, and contamination control in critical environments like healthcare and pharmaceuticals.
European Vacuum Testing
European Vacuum Testing (EVT) evaluates HVAC duct cleanliness by collecting dust from a defined area using a vacuum and pre-weighed filter capsule. The collected dust is weighed to assess cleanliness levels per BS EN 15780 and TR19, determining if cleaning is needed.
Active Air Sampling
Active air sampling uses a calibrated pump to draw a measured volume of air through a microbial collection device, such as an agar plate. It quantitatively detects airborne bacteria and fungi, ensuring cleanroom compliance and protecting both crucial product and patient safety.
HEPA Filter DOP Testing
HEPA filter testing to ISO14644-3 uses photometry to measure aerosol levels upstream and downstream, verifying filter integrity. This ensures cleanroom compliance, prevents contamination, and protects product quality and patient safety in regulated, high-precision environments.
Asset & System Surveys
Annual verifications to HTM 03-01 ensure healthcare ventilation systems meet strict airflow, pressure, and filtration standards. Certified experts assess system performance to maintain regulatory compliance, enhance patient safety, support infection control, and prevent disruptions in critical areas like operating theatres and isolation rooms.
© Property Solutions Management Group Ltd









